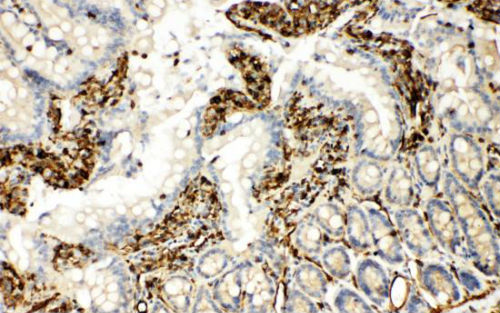

TRAF6 是一类泛素连接酶(E3 ligase),它是先天免疫信号传递过程中十分重要的蛋白。在免疫细胞接受外界刺激(pamps)时,TRAF6会进行同源聚合并"自行"k-63泛素化。泛素化后的TRAF6会招募TAK1以及辅助蛋白TAB1,TAB2,从而激活IKK复合体,最终导致NF-kB的激活。然而,目前还没有关于TRAF6在泛素化一外其它方面的研究。另外一方面,MSK4是一类"生发中心蛋白激酶"家族的成员,它广泛参与了细胞内的代谢活动。最近,来自中国科学院上海生物研究所的周兆才研究组与王琛研究组发现MSK4参与了TRAF6的活性调控。相关研究成果发表在《nature:immunology》杂志上。
作者首先发现这样一个现象:患有脓毒症(一种系统性炎症)的患者外周血细胞中MST4的表达量要明显低于健康人群,其IL-6的表达量与MST4的表达量具有高度的反向相关性。之后,作者通过体外LPS刺激不同类型的小鼠原代巨噬细胞以及体内刺激小鼠并检测不同组织器官中的MST-4的表达量。结果显示:在接受刺激之后,MST4会有一个快速的上升。
为了研究MST4在免疫应答过程中的作用,作者通过RNA干扰的方式人为地调低了MST4的表达量,结果显示,MST4的下调使巨噬细胞在接受LPS刺激时产生更多的IL-6与TNF-a。一系列的相关实验证明了MST4对于一直免疫反应的作用。
那么MSK4是如何行使功能的呢?作者首先猜想MST4的磷酸化活性可能提供了帮助。因此,他们通过突变的方式得到了两种不同的MST4突变体:稳定活化(T 198 E),稳定失活(K 53 R)。通过比较不同的MST4在相应先天免疫信号中的差异,作者发现TE较野生MST4更能抑制TNF-a与IL-6的释放,然而KR则完全失去了抑制活性。以上实验结果说明MST4抑制免疫活性的能力是依赖于其激酶活性。
作者利用NF-KB报告系统对MST4的分子机制做了进一步研究。结果显示,MST4能够抑制TRAF6引起的NF-kB激活,说明MST4的作用位点位于TRAF6下游。之后,作者通过免疫共沉淀的方法发现MST4与TRAF6存在相互作用。之后,作者发现在MST4存在的情况下,TRAF6的泛素化收到了明显的抑制。进一步通过突变的方法使TRAF6本身的泛素化能力丧失,发现不论MST4存在与否TRAF6均不能得到泛素化。以上结果说明MST4的确抑制了TRAF6的自体泛素化过程。之后作者还证明了MST4抑制TRAF6泛素化的作用依赖于其磷酸化的能力。最后,作者通过生化的手段证明MST4能够造成TRAF6 T463与T486位的磷酸化。这一磷酸化对于TRAF6的自体聚合与自体泛素化十分重要。
综上,作者通过一系列体外的生化实验证明了MST4能够通过磷酸化TRAF6 463与463位的苏氨酸,从而抑制其在受到上游信号刺激的条件下引起的自体聚集与自体泛素化,从而达到抑制下游NF-kB激活的效应。







